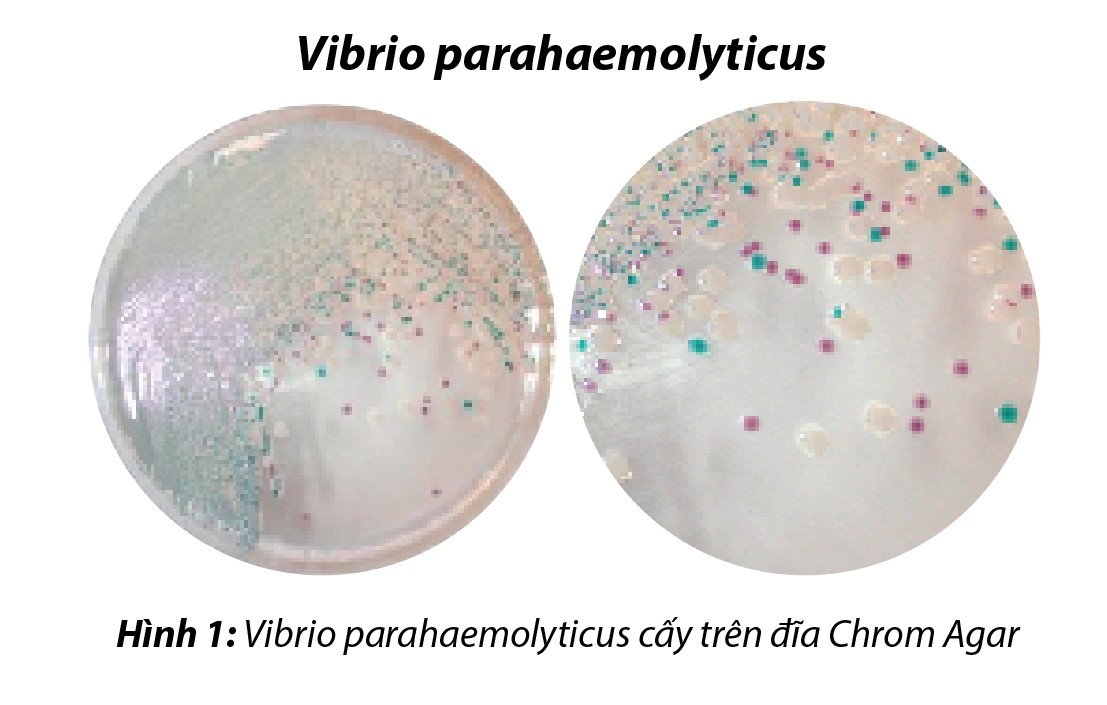

CÁC BỆNH THƯỜNG GẶP TRÊN TÔM NUÔI
I. PHÒNG TRỊ BỆNH GAN TỤY TRÊN TÔM THẺ
Tác nhân gây bệnh:
– Bệnh hoại tử gan tụy trên tôm (AHPND) hay còn gọi là hội chứng tôm chết sớm (EMS).
– Hội chứng liên quan đến việc quản lý môi trường ao nuôi tôm, trong đó nhóm vi khuẩn Vibrio parahaemolyticus là nguyên nhân chính gây bệnh ở tôm.
Dấu hiệu bệnh lý: có thể chia bệnh làm 2 giai đoạn
– Giai đoạn 1 (Tôm chết dưới 30 ngày tuổi): Nguyên nhân lúc này có thể do tôm giống kém chất lượng và có khả năng đã nhiễm bệnh từ trại giống, hoặc việc cải tạo ao không tốt, lây nhiễm từ vật chủ trung gian.
– Giai đoạn 2 (Tôm chết ở giai đoạn 31-60 ngày tuổi): Giai đoạn này tôm chết do nhiễm bệnh thì nguyên nhân nằm ở quản lý ao nuôi kém, dư thừa thức ăn, nhiều chất thải hữu cơ,… Dẫn đến mật độ vi khuẩn Vibrio sp. gây hại tăng cao.

II. PHÒNG TRỊ BỆNH PHÂN TRẮNG, ĐƯỜNG RUỘT PHÂN NHÃO, PHÂN LỎNG, RUỘT ĐỨT KHÚC, TRỐNG RUỘT TRÊN TÔM
1.1 Phòng bệnh: gan tụy chết sớm trêm tôm bằng kiểm soát vi khuẩn Vibrio 7-10 ngày 1 đợt
Xử lý nước phòng định kỳ:
– Sáng: thuốc KB 90 khử khuẩn nước ao nuôi phòng bệnh 1 lọ 500g cho 3000m3 nước ao nuôi, hòa tan thuốc vào 30 lít nước sạch tạt đều quanh ao nuôi.
– Chiều: thuốc KC 986 viên sủi có trợ thêm oxy khử khuẩn tầng đáy phòng bệnh 500g cho 3000m3 nước ao nuôi, vãi chìm viên sủi chìm xuống đáy ao nuôi đều quanh ao nuôi sẽ hiệu quả cao (phần lớn mầm bệnh gây hại cho tôm chủ yếu ký sinh dưới đáy ao nơi mà các thuốc sát trùng thông thường khuếch tán xuống được để tiêu diệt đặc biệt là các ao nuôi có mực nước sâu do đó viên sủi ném chìm đấy là một giải pháp tốt nhất để kiểm soát mầm bệnh dưới đáy ao gây hại trực tiếp cho tôm).
Cho tôm ăn phòng theo đợt phòng:
– Thuốc bằng HAN MET 3-5g/1kg thức ăn 3 ngày liên tiếp, ngày 2 cữ khoảng 10-15 ngày nên cho tôm ăn phòng 1 đợt
– Thuốc BIN PHÂN TRẮNG cho tôm ăn bệnh đường ruột, phân trắng phòng 2 ngày 1 bữa ăn
– Cho ăn hàng ngày 1 cữ ăn vào buổi chiều tối Vitamin tổng hợp nâng sức đề kháng cho tôm.
+ Sau quá trình xử lý thuốc nên cấy vi sinh ủ BIN LACTO để ổn định hệ vi sinh có ích cho môi trường ao nuôi và xử lý làm sạch nước và đáy ao nuôi, liều lượng:
-1 gói BIN LACTO +30 Lít nước sạch ủ kín 2 ngày không cần mật đường và các phụ gia khác sau ủ 1-3 lít vi sinh cho 1000m3 ao nuôi, 3 ngày 1 đợt
2.2. Trị bệnh cho tôm kiểm soát vi khuẩn Vibrio spp gây bệnh hoại tử gan tụy 3 ngày 1 đợt:
Khử trùng diệt khuẩn tiêu diệt mầm bệnh gây bệnh gan tụy cấp:
– Buổi trưa: thuốc KB 90 khử trùng nước ao nuôi phòng bệnh 1 lọ 500g cho 3000m3 nước ao nuôi, hòa tan thuốc vào 30 lít nước sạch tạt đều quanh ao nuôi.
– Buôi trưa hoặc chiều tối: thuốc KC 986 viên sủi tiêu diệt mầm bệnh tầng đáy phòng bệnh 500g cho 3000m3 nước ao nuôi, vãi chìm viên sủi chìm xuống đáy ao nuôi đều quanh ao nuôi sẽ hiệu quả cao (phần lớn mầm bệnh gây hại cho tôm chủ yếu ký sinh dưới đáy ao nơi mà các thuốc khử trùng thông thường khuếch tán xuống được để tiêu diệt đặc biệt là các ao nuôi có mực nước sâu do đó viên sủi ném chìm đấy là một giải pháp tốt nhất để kiểm soát mầm bệnh dưới đáy ao gây hại trực tiếp cho tôm)
Cho tôm ăn đặc trị bệnh gan tụy cấp, hội chứng chết sớm EMS:
– Cho tôm ăn thuốc HAN MET + BIN PHÂN TRẮNG 5-7g/kg thức ăn cho ăn liên tiếp 5-7 ngày, 2 cữ ăn 1 ngày sau khi cá khỏi quay về liều phòng định kỳ.
– Cho ăn hàng ngày 1 cữ ăn vào buổi chiều tối Vitamin tổng hợp nâng sức đề kháng cho tôm.
+ Sau quá trình xử lý thuốc nên cấy vi sinh ủ BIN LACTO để ổn định hệ vi sinh có ích cho môi trường ao nuôi và xử lý làm sạch nước và đáy ao nuôi, liều lượng:
-1 gói BIN LACTO +30 Lít nước sạch ủ kín 2 ngày không cần sử dụng mật đường và các phụ gia khác sau ủ 1-3 lít vi sinh cho 1000m3 ao nuôi, 3 ngày 1 đợt
– Tác nhân gây bệnh do: có 4 tác nhân chính gây bệnh phân trắng đường ruột:
+ Do thức ăn: Thức ăn không tốt, thức ăn bị nhiễm nấm mốc, độc tố… tôm ăn phải thức ăn không tốt trên sẽ bị bệnh đường ruột ( bệnh phân trắng).
+ Do tảo độc: Tôm ăn phải tảo độc, tảo tiết ra enzyme làm tê liệt lớp biểu mô ruột, làm ruột không hấp thu thức ăn được,
+ Do tôm bị bệnh. Ký sinh trùng (Gregarine) bám trên thành ruột, tôm bị bệnh đường ruột.
+ Do vi khuẩn: Vi khuẩn gây bệnh phân trắng thường gặp thuộc các chuẩn Vibrio spp. Có thể nói rằng môi trường ô nhiễm là nguyên nhân tạo điều kiện cho tảo độc, vi khuẩn, virus phát triển và xâm nhập vào cơ thể tôm.
– Dấu hiệu bệnh lý: Người nuôi cần quan sát bên ngoài thấy tôm bình thường nhưng khi quan sát kỹ hoạt động của tôm và môi trường ao nuôi, sẽ phát hiện các trường hợp sau cho thấy dấu hiệu tôm bị phân trắng:
+Tôm có biểu hiện ăn yếu (hoặc bỏ ăn nếu bị bệnh nặng), sợi phân tôm mầu trắng nổi lên mặt nước và tập trung nhiều ở cuối hướng gió. Khi quan sát đường ruột tôm thấy trống thức ăn hoặc thức ăn bị đứt khúc. Kiểm tra bằng Phương pháp mô học của mẫu tôm bị bệnh phân trắng thì thấy gan cũng bị tổn thương, tế bào gan bị chết từng điểm bong ra. Hệ thống đường ruột bị viêm nhiễm nặng không hấp thụ được thức ăn, phân tôm có màu trắng, thịt tôm không chứa đầy vỏ, vỏ mềm.
+Bệnh phân trắng nếu phát hiện bệnh sớm và xử lý kịp thời, khả năng bắt mồi của tôm sẽ trở lại bình thường. Nếu không xử lý kịp thời cường độ bỏ ăn ngày càng cao. Tôm bệnh ngày một gia tăng, đến mức độ nào đó sẽ thấy hiện tượng tôm chết rải rác ở đáy ao, từ vài con đến hàng trăm con/ ngày và mỗi ngày một tăng



2.1 Phòng bệnh phân trắng đường ruột cho tôm nên duy trì trong thời gian nuôi:
Định kỳ khử khuẩn và cho tôm ăn phòng bệnh phân trắng 7-10 ngày 1 đợt:
+ Sáng khử khuẩn nước: thuốc KB 90 khử khuẩn nước ao nuôi phòng bệnh 1 lọ 500g cho 3000m3 nước ao nuôi, hòa tan thuốc vào 30 lít nước sạch tạt đều quanh ao nuôi.
+ Chiều khử khuẩn đáy: thuốc KC 986 viên sủi có trợ thêm oxy khử khuẩn tầng đáy phòng bệnh 500g cho 3000m3 nước ao nuôi, vãi chìm viên sủi chìm xuống đáy ao nuôi đều quanh ao nuôi sẽ hiệu quả cao (phần lớn mầm bệnh gây hại cho tôm chủ yếu ký sinh dưới đáy ao nơi mà các thuốc sát trùng thông thường khuếch tán xuống được để tiêu diệt đặc biệt là các ao nuôi có mực nước sâu do đó viên sủi ném chìm đấy là một giải pháp tốt nhất để kiểm soát mầm bệnh dưới đáy ao gây hại trực tiếp cho tôm).
Cho tôm ăn phòng theo đợt:
– Thuốc bằng BIN PHÂN TRẮNG 2 ngày 1 bữa phòng, liều 3-5g/kg thức ăn;
– Trường hợp gặp thời tiết nắng nóng lâu ngày và gặp mưa đột ngột cần phòng ngày cho tôm ăn BIN PHÂN TRẮNG ngày 2 cữ và ăn phòng liên tiếp 3 ngày để phòng bệnh đường ruột và phân trắng cho tôm;
– Cho ăn hàng ngày 1 cữ ăn vào buổi chiều tối Vitamin tổng hợp nâng sức đề kháng cho tôm.
+ Sau quá trình xử lý thuốc nên cấy vi sinh ủ BIN LACTO để ổn định hệ vi sinh có ích cho môi trường ao nuôi và xử lý làm sạch nước và đáy ao nuôi, liều lượng:
-1 gói BIN LACTO +30 Lít nước sạch ủ kín 2 ngày không cần mật đường và các phụ gia khác sau ủ 1-3 lít vi sinh cho 1000m3 ao nuôi, 3 ngày 1 đợt
– Cho tôm ăn men BIN LACTO (sau ủ) thay men tiêu hóa 5 ngày liên tiếp rồi nghỉ 2 ngày trong 1 tuần và duy trì các tuần tiếp theo đến hết vụ nuôi để ổn định hệ vi sinh và phục hồi đường ruột cho tôm.
2.2 Đặc trị bệnh phân trắng và đường ruột:
Khử trùng tiêu diệt mầm bệnh gây phân trắng, bệnh đường ruột cần tiến hành 3 ngày 1 đợt
– Buổi sáng: thuốc KB 90 khử nấm nước ao nuôi phòng bệnh 1 lọ 500g cho 3000m3 nước ao nuôi, hòa tan thuốc vào 30 lít nước sạch tạt đều quanh ao nuôi.
– Buôi chiều: thuốc KC 986 viên sủi tiêu diệt mầm bệnh tầng đáy phòng bệnh 500g cho 3000m3 nước ao nuôi, vãi chìm viên sủi chìm xuống đáy ao nuôi đều quanh ao nuôi sẽ hiệu quả cao (phần lớn mầm bệnh gây hại cho tôm chủ yếu ký sinh dưới đáy ao nơi mà các thuốc khử trùng thông thường khuếch tán xuống được để tiêu diệt đặc biệt là các ao nuôi có mực nước sâu do đó viên sủi ném chìm đấy là một giải pháp tốt nhất để kiểm soát mầm bệnh dưới đáy ao gây hại trực tiếp cho tôm)
Cho tôm ăn đặc trị bệnh phân trắng đường ruột:
– Cho tôm ăn thuốc BIN PHÂN TRẮNG liều cho ăn 7-10g/kg thức ăn cho ăn liên tiếp 5-7 ngày, 2 cữ ăn 1 ngày sau khi cá khỏi quay về liều phòng định kỳ.
– Cho ăn hàng ngày 1 cữ ăn vào buổi chiều tối Vitamin tổng hợp nâng sức đề kháng cho tôm.
+ Sau quá trình xử lý thuốc nên cấy vi sinh ủ BIN LACTO để ổn định hệ vi sinh có ích cho môi trường ao nuôi và xử lý làm sạch nước và đáy ao nuôi, liều lượng:
-1 gói BIN LACTO +30 Lít nước sạch ủ kín 2 ngày không cần sử dụng mật đường và các phụ gia khác sau ủ 1-3 lít vi sinh cho 1000m3 ao nuôi, 3 ngày 1 đợt
– Sau khi tôm khỏi bệnh cho tôm ăn men BIN LACTO (sau ủ) thay men tiêu hóa 5 ngày liên tiếp rồi nghỉ 2 ngày trong 1 tuần và duy trì các tuần tiếp theo đến hết vụ nuôi để ổn định hệ vi sinh và phục hồi đường ruột cho tôm.
III. PHÒNG TRỊ BỆNH ĐEN MANG
Tác nhân gây bệnh: Do đáy ao môi trường ô nhiễm gây đen mang cho tôm, do tôm bị nhiễm ký sinh trùng, nhiễm nấm…
Dấu hiệu bệnh lý: tôm bị đen mang hô hấp kém làm tôm còi cọc chậm lớn và không có giá trị thương phẩm sau khi thu hoặc

Đặc trị bệnh đen mang trên tôm:
Xử lý 3 ngày liên tiếp mang tôm sẽ hết sạch đen mang:
– Sáng: thuốc KB 90 khử khuẩn nước ao nuôi phòng bệnh 1 lọ 500g cho 3000m3 nước ao nuôi, hòa tan thuốc vào 30 lít nước sạch tạt đều quanh ao nuôi.
– Chiều: thuốc KC 986 viên sủi có trợ thêm oxy khử khuẩn tầng đáy phòng bệnh 500g cho 3000m3 nước ao nuôi, vãi chìm viên sủi chìm xuống đáy ao nuôi đều quanh ao nuôi sẽ hiệu quả cao (phần lớn mầm bệnh gây hại cho tôm chủ yếu ký sinh dưới đáy ao nơi mà các thuốc sát trùng thông thường khuếch tán xuống được để tiêu diệt đặc biệt là các ao nuôi có mực nước sâu do đó viên sủi ném chìm đấy là một giải pháp tốt nhất để kiểm soát mầm bệnh dưới đáy ao gây hại trực tiếp cho tôm).
+ Sau quá trình xử lý thuốc nên cấy vi sinh ủ BIN LACTO để ổn định hệ vi sinh có ích cho môi trường ao nuôi và xử lý làm sạch nước và đáy ao nuôi, liều lượng:
-1 gói BIN LACTO +30 Lít nước sạch ủ kín 2 ngày không cần mật đường và các phụ gia khác sau ủ 1-3 lít vi sinh cho 1000m3 ao nuôi, 3 ngày 1 đợt
III. PHÒNG TRỊ BỆNH PHỒNG MANG KÊNH MANG
Tác nhân gây bệnh: do tôm bị nhiễm ký sinh trùng giống như miếng thạch rau câu (trùng lệch miệng)
Dấu hiệu bệnh lý: tôm bị mất hô hấp ngơ lên mặt nước rồi yếu chết, tôm bị kênh mang không khép được mang.

Đặc trị bệnh kênh mang phồng mang trên tôm:
Xử lý 3 ngày liên tiếp mang tôm sẽ hết sạch đen mang:
– Sáng: thuốc KB 90 khử khuẩn nước ao nuôi phòng bệnh 1 lọ 500g cho 3000m3 nước ao nuôi, hòa tan thuốc vào 30 lít nước sạch tạt đều quanh ao nuôi.
– Trưa: thuốc KC 986 viên sủi có trợ thêm oxy khử khuẩn tầng đáy phòng bệnh 500g cho 3000m3 nước ao nuôi, vãi chìm viên sủi chìm xuống đáy ao nuôi đều quanh ao nuôi sẽ hiệu quả cao (phần lớn mầm bệnh gây hại cho tôm chủ yếu ký sinh dưới đáy ao nơi mà các thuốc sát trùng thông thường khuếch tán xuống được để tiêu diệt đặc biệt là các ao nuôi có mực nước sâu do đó viên sủi ném chìm đấy là một giải pháp tốt nhất để kiểm soát mầm bệnh dưới đáy ao gây hại trực tiếp cho tôm).
– Chiều tối: thuốc BIN 800 1 lọ 800g/1000m3 chạy quạt mạnh sau khi tạt thuốc.
+ Sau quá trình xử lý thuốc nên cấy vi sinh ủ BIN LACTO để ổn định hệ vi sinh có ích cho môi trường ao nuôi và xử lý làm sạch nước và đáy ao nuôi, liều lượng:
-1 gói BIN LACTO +30 Lít nước sạch ủ kín 2 ngày không cần mật đường và các phụ gia khác sau ủ 1-3 lít vi sinh cho 1000m3 ao nuôi, 3 ngày 1 đợt
IV. PHÒNG TRỊ BỆNH TÔM BỊ ĐỐM ĐEN, MÒN PHỤ BỘ, CỤT RÂU
Tác nhân gây bệnh: do ao tôm bị ô nhiễm độc tố tăng cao, do tôm bị nhiễm khuẩn ăn mòn phụ bộ…
Dấu hiệu bệnh lý: tôm xuất hiện các vết đốm đen (đóng khói đèn), bị cụt râu, bị mòn các phụ bộ tôm khó lột vỏ và tỉ lệ rớt đáy cao nếu không xử lý kịp thời.

Xử lý 3 ngày liên tiếp xử lý tôm bị đốm đen, mòn phụ bộ, cụt râu:
– Sáng: thuốc KB 90 khử khuẩn nước ao nuôi phòng bệnh 1 lọ 500g cho 3000m3 nước ao nuôi, hòa tan thuốc vào 30 lít nước sạch tạt đều quanh ao nuôi.
– Trưa: thuốc KC 986 viên sủi có trợ thêm oxy khử khuẩn tầng đáy phòng bệnh 500g cho 3000m3 nước ao nuôi, vãi chìm viên sủi chìm xuống đáy ao nuôi đều quanh ao nuôi sẽ hiệu quả cao (phần lớn mầm bệnh gây hại cho tôm chủ yếu ký sinh dưới đáy ao nơi mà các thuốc sát trùng thông thường khuếch tán xuống được để tiêu diệt đặc biệt là các ao nuôi có mực nước sâu do đó viên sủi ném chìm đấy là một giải pháp tốt nhất để kiểm soát mầm bệnh dưới đáy ao gây hại trực tiếp cho tôm).
– Chiều tối: thuốc BIN VIKON 1 lọ 1000g/1000m3 chạy quạt mạnh sau khi tạt thuốc.
– Cho tôm ăn: thuốc bằng HAN MET liều ăn 3-5g/1kg thức ăn 3-5 ngày liên tiếp, ngày 2 cữ ăn.
– Sau quá trình xử lý thuốc nên cấy vi sinh ủ BIN LACTO để ổn định hệ vi sinh có ích cho môi trường ao nuôi và xử lý làm sạch nước và đáy ao nuôi, liều lượng:
+1 gói BIN LACTO +30 Lít nước sạch ủ kín 2 ngày không cần mật đường và các phụ gia khác sau ủ 1-3 lít vi sinh cho 1000m3 ao nuôi, 3 ngày 1 đợt
V. PHÒNG TRỊ BỆNH HOẠI TỬ CƠ TRÊN TÔM
Tác nhân gây bệnh: bị nhiễm vi bào tử trùng, nhiễm khuẩn gây hoại tử cơ
Dấu hiệu bệnh lý: trên cơ thể tôm xuất hiện những vùng đục cơ hoại tử cơ trên thân tôm



Khử trùng tiêu diệt mầm bệnh 2-3 ngày liên tiếp
– Sáng: thuốc KB 90 khử khuẩn nước ao nuôi phòng bệnh 1 lọ 500g cho 3000m3 nước ao nuôi, hòa tan thuốc vào 30 lít nước sạch tạt đều quanh ao nuôi.
– Trưa: thuốc KC 986 viên sủi có trợ thêm oxy khử khuẩn tầng đáy phòng bệnh 500g cho 3000m3 nước ao nuôi, vãi chìm viên sủi chìm xuống đáy ao nuôi đều quanh ao nuôi sẽ hiệu quả cao (phần lớn mầm bệnh gây hại cho tôm chủ yếu ký sinh dưới đáy ao nơi mà các thuốc sát trùng thông thường khuếch tán xuống được để tiêu diệt đặc biệt là các ao nuôi có mực nước sâu do đó viên sủi ném chìm đấy là một giải pháp tốt nhất để kiểm soát mầm bệnh dưới đáy ao gây hại trực tiếp cho tôm).
+ Sau quá trình xử lý thuốc nên cấy vi sinh ủ BIN LACTO để ổn định hệ vi sinh có ích cho môi trường ao nuôi và xử lý làm sạch nước và đáy ao nuôi, liều lượng:
-1 gói BIN LACTO +30 Lít nước sạch ủ kín 2 ngày không cần mật đường và các phụ gia khác sau ủ 1-3 lít vi sinh cho 1000m3 ao nuôi, 3 ngày 1 đợt
Cho tôm ăn thuốc đặc trị:
– Cho tôm ăn tổ hợp HAN MET + BIN PHÂN TRẰNG 3-5g cho 1kg thức ăn, ăn liên tục 5 ngày liên tiếp ngày 2 bữa, sau khi tôm khỏi bệnh giảm tỉ lệ rớt đáy quay về ăn theo liều phòng.
Tham khảo sản phẩm phòng trị bệnh: https://binopharvn.com.vn/?product_cat=san-pham-cho-tom
Biên tập bởi: Các Kỹ sư NTTS BINOPHARVN
Liên hệ chúng tôi để được tư vấn xử lý khi cá bệnh:
CÔNG TY TNHH BINOPHAR VIỆT NAM
Địa chỉ: Thôn Yên Quán – Xã Tân Phú – Huyện Quốc Oai – Hà Nội.
Tư vấn kỹ thuật: 0835.552.186
Email: binopharvn@gmail.com





